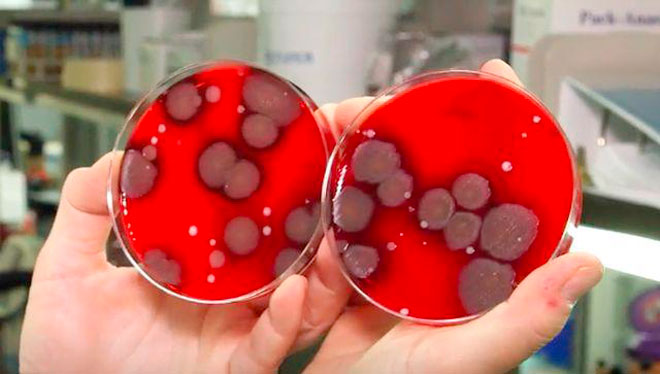

Mnogi od nas nose svoje mobilne telefone svuda sa sobom, uključujući i kupatilo. Mogu li neki od opasnih mikroorganizama da pređu na ove uređaje?
Magazin Biznis insajder odlučio je da sprovede mali eksperiment – sakupio je 19 telefona i predao ih doktorki Suzan Vitijer, direktorki Odeljenja za mikrobiologiju na Kolumbijskom univerzitetu u Njujorku.
Uzet je bris prednje i zadnje strane svakog telefona, a rezultati su pokazali da je od 38 uzoraka 34 bilo kontaminirano.
Ono što je naročito zabrinjavajuće je da su na pojedinim uređajima pronađene gram pozitivne bakterije, poput bacila i stafilokoke. Ukoliko dospeju u kontakt sa ranom, posekotinom ili nekom drugom vrstom oštećenja na koži, ove vrste bakterija mogle bi da izazovu tešku infekciju.
Od 19 ispitanika, 75 odsto je priznalo da nose telefon u toalet, a na četiri uzorka pokazala su prisustvo bakterija koje se povezuju sa fekalijama. Tri uzorka sadržala su bakterije otporne na antibiotike (MRSA).
Na 10,5 odsto telefona pronađeno je 0 bakterijskih kolonija, a na 10.5 odsto manje od 10 kolonija. Deset do dvadeset kolonija sadržalo je 26 odsto pametnih telefona, 20 do 50 kolonija 31,5 odsto mobilnih, a 21, 5 odsto uređaja bilo je dom više od 50 različitih kolonija.
Naravno, reč je o izuzetno malom uzorku, što znači da se rezultati ne odnose nužno na celu populaciju, ističe doktorka Vitijer.
Izvor: B92